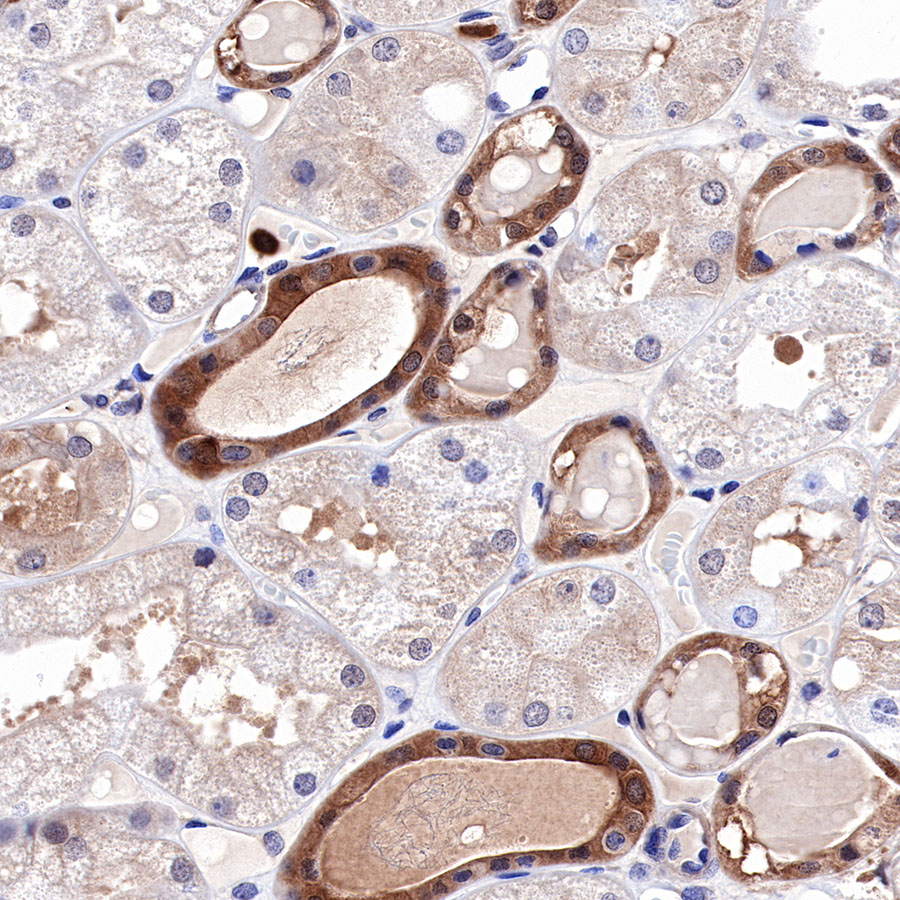
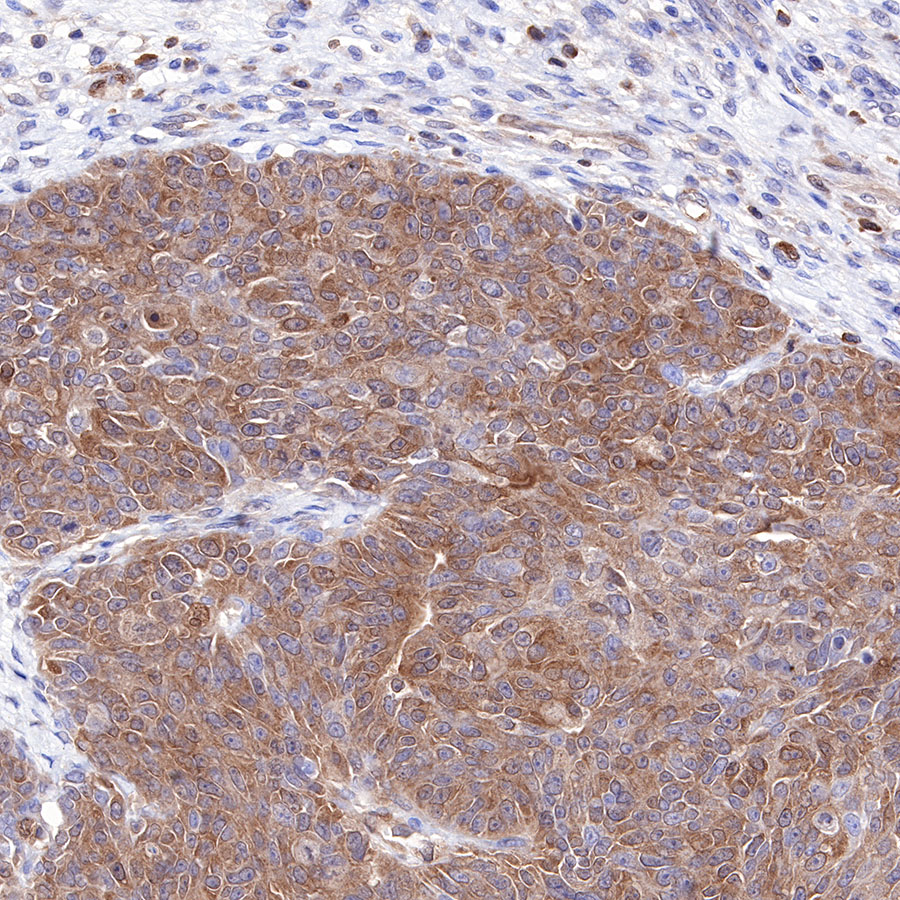
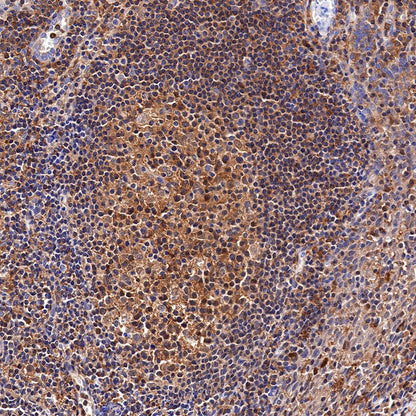

Product Details
Product Details
Product Specification
Host | Rabbit |
Antigen | MEK1 |
Synonyms | Dual specificity mitogen-activated protein kinase kinase 1, MAP kinase kinase 1, MAPKK 1, MKK1, ERK activator kinase 1, MAPK/ERK kinase 1 |
Immunogen | Synthetic Peptide |
Location | Cytoplasm, Cytoskeleton, Nucleus, Membrane |
Accession | Q02750 |
Clone Number | SDT-308-32 |
Application | WB, IHC-P, ICC, ICFCM, IP |
Reactivity | Hu |
Purification | Protein A |
Concentration | 0.5 mg/ml |
Physical Appearance | Liquid |
Storage Buffer | PBS, 40% Glycerol, 0.05% BSA, 0.03% Proclin 300 |
Stability & Storage | 12 months from date of receipt / reconstitution, -20 °C as supplied. |
Dilution
application | dilution | species |
WB | 1:1000-1:10000 | null |
IHC-P | 1:500 | null |
ICC | 1:1000 | null |
IP | 1:50 | null |
ICFCM | 1:500 | null |
Background
Mitogen-activated protein kinase kinases 1 and 2 (MEK1/2) are the crucial part of the RAS-RAF-MEK-ERK pathway (or ERK pathway), which is involved in the regulation of various cellular processes including proliferation, survival, and differentiation et al. Targeting MEK has become an important strategy for cancer therapy, and 4 MEK inhibitors (MEKis) have been approved by FDA to date [PMID: 33774345].
Picture
Picture
Western Blot

FC

Flow cytometric analysis of 4% PFA fixed 90% methanol permeabilized HeLa (Human cervix adenocarcinoma epithelial cell) labelling MEK1 antibody at 1/500 dilution (0.1 μg) / (Red) compared with a Rabbit monoclonal IgG (Black) isotype control and an unlabelled control (cells without incubation with primary antibody and secondary antibody) (Blue). Goat Anti - Rabbit IgG Alexa Fluor® 488 was used as the secondary antibody.
IP
MEK1 Rabbit mAb at 1/50 dilution (1 µg) immunoprecipitating MEK1 in 0.4 mg A431 whole cell lysate.
Western blot was performed on the immunoprecipitate using MEK1 Rabbit mAb at 1/1000 dilution.
Secondary antibody (HRP) for IP was used at 1/400 dilution.
Lane 1: A431 whole cell lysate 20 µg (Input)
Lane 2: MEK1 Rabbit mAb IP in A431 whole cell lysate
Lane 3: Rabbit monoclonal IgG IP in A431 whole cell lysate
Predicted MW: 43 kDa
Observed MW: 43 kDa
Immunohistochemistry

Immunocytochemistry